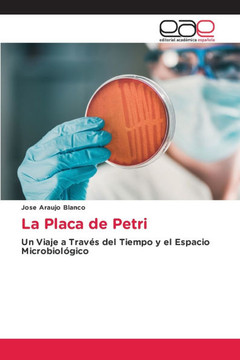

Edicoes Nosso Conhecimento
A placa de Petri
Product Code:
9786207929085
ISBN13:
9786207929085
Condition:
New
$87.00
$84.59
Sale 3%

A placa de Petri
$87.00
$84.59
Sale 3%
A Placa de Petri: Uma Viagem no Tempo e no Espa?o da Microbiologia: Nesta obra, exploramos a fascinante hist?ria e evolu??o da placa de Petri, um elemento essencial na microbiologia. Desde os seus prim?rdios, detalhados no Cap?tulo 1, descobrimos as ra?zes microsc?picas e a viagem atrav?s do tempo deste dispositivo. Discutimos as primeiras aplica??es em microbiologia e bacteriologia, que revolucionaram a ci?ncia com esta ferramenta inovadora.No cap?tulo 2, sobre a era contempor?nea, analisamos a sua aplica??o na ind?stria alimentar, na ind?stria farmac?utica, na ecologia microbiana e na biotecnologia, bem como a sua intersec??o com a engenharia gen?tica e a bioinform?tica. Al?m disso, exploramos o seu papel na vigil?ncia epidemiol?gica e no controlo de doen?as, bem como o seu impacto na educa??o e divulga??o cient?ficas.Finalmente, no cap?tulo 3, navegamos pelo futuro da placa de Petri. Investigamos as tend?ncias emergentes em termos de tecnologia, automa??o, intelig?ncia artificial e novos modelos te?ricos. Analisamos os desafios ?ticos e regulamentares que se colocam ? investiga??o microbiol?gica futura.
Author: Jose Araujo Blanco |
Publisher: Edicoes Nosso Conhecimento |
Publication Date: Aug 12, 2024 |
Number of Pages: 124 pages |
Binding: Paperback or Softback |
ISBN-10: 620792908X |
ISBN-13: 9786207929085 |